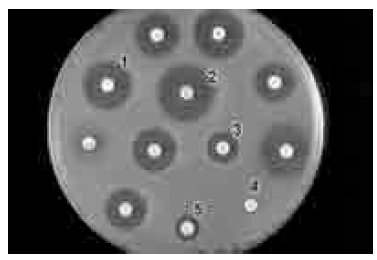
enunciado 1758487-1

Foram encontradas 2.158 questões.
Em relação aos principais processos de esterilização e desinfecção atualmente empregados, julgue os seguintes itens.
Apenas após tratamento por irradiação com raios gama é possível a esterilização absoluta dos materiais a serem empregados em procedimentos microbiológicos.
Provas

Considerando a figura de ensaio biológico apresentada acima, julgue os itens a seguir.
Na realização desse ensaio biológico, a bactéria a ser testada é misturada ao meio de cultura antes da sua solidificação.
Provas

Considerando a figura de ensaio biológico apresentada acima, julgue os itens a seguir.
Na figura acima, a bactéria em estudo é resistente ao antimicrobiano empregado na concentração representada pelo disco indicado pelo número 2.
Provas
Considerando a figura de ensaio biológico apresentada acima, julgue os itens a seguir.
A figura representa um antibiograma, um tipo de ensaio biológico que permite avaliar a suscetibilidade/resistência de uma bactéria a um ou mais agentes antimicrobianos.
Provas
Em um tubo de ensaio, adicionar 100 microlitros de hemácias do recém-nascido a ser testado, que já foram previamente lavadas para remoção de possíveis anticorpos nãoligados; adicionar, em seguida, 100 microlitros de anti-IgG humana; centrifugar o tubo a 1.000 rpm por 2 min à temperatura ambiente; para visualizar com maior precisão se houve aglutinação, derramar o sangue centrifugado em uma lâmina de microscópio.
Considerando os procedimentos indicados no protocolo apresentado acima, julgue os itens que se seguem.Se não ocorrer aglutinação, é correto concluir que não houve passagem de anticorpos maternos anti-D através da placenta.
Provas
Em um tubo de ensaio, adicionar 100 microlitros de hemácias do recém-nascido a ser testado, que já foram previamente lavadas para remoção de possíveis anticorpos nãoligados; adicionar, em seguida, 100 microlitros de anti-IgG humana; centrifugar o tubo a 1.000 rpm por 2 min à temperatura ambiente; para visualizar com maior precisão se houve aglutinação, derramar o sangue centrifugado em uma lâmina de microscópio.
Considerando os procedimentos indicados no protocolo apresentado acima, julgue os itens que se seguem.Por meio desses procedimentos, anticorpos maternos que atravessaram a placenta podem ser detectados ligados nas hemácias Rh negativas do bebê.
Provas
Um homem que pertence ao grupo sanguíneo AB positivo é casado com uma mulher que pertence ao grupo O negativo. Considerando essa situação, julgue os seguintes itens.
Ao se considerar o fator Rh, há possibilidade de a esposa dar à luz uma criança com eritroblastose fetal.
Provas
Um homem que pertence ao grupo sanguíneo AB positivo é casado com uma mulher que pertence ao grupo O negativo. Considerando essa situação, julgue os seguintes itens.
Todos os filhos desse casal serão obrigatoriamente Rh positivo.
Provas
Um homem que pertence ao grupo sanguíneo AB positivo é casado com uma mulher que pertence ao grupo O negativo. Considerando essa situação, julgue os seguintes itens.
Esse casal poderá gerar filhos pertencentes aos grupos AB e O.
Provas
Um homem que pertence ao grupo sanguíneo AB positivo é casado com uma mulher que pertence ao grupo O negativo. Considerando essa situação, julgue os seguintes itens.
Em caso de emergência médica, o marido, na falta de sangue do tipo AB, pode receber transfusão usando o sangue da esposa.
Provas
Caderno Container